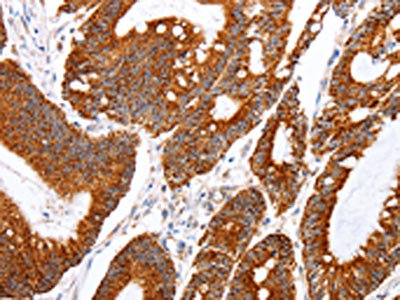

TNFAIP1 Antibody
-
中文名稱:TNFAIP1兔多克隆抗體
-
貨號(hào):CSB-PA934815
-
規(guī)格:¥1100
-
圖片:
-
The image on the left is immunohistochemistry of paraffin-embedded Human colon cancer tissue using CSB-PA934815(TNFAIP1 Antibody) at dilution 1/25, on the right is treated with fusion protein. (Original magnification: ×200)
-
The image on the left is immunohistochemistry of paraffin-embedded Human thyroid cancer tissue using CSB-PA934815(TNFAIP1 Antibody) at dilution 1/25, on the right is treated with fusion protein. (Original magnification: ×200)
-
-
其他:
產(chǎn)品詳情
-
Uniprot No.:
-
基因名:TNFAIP1
-
別名:TNFAIP1 antibody; BACURD2 antibody; EDP1BTB/POZ domain-containing adapter for CUL3-mediated RhoA degradation protein 2 antibody; hBACURD2 antibody; BTB/POZ domain-containing protein TNFAIP1 antibody; Protein B12 antibody; Tumor necrosis factor antibody; alpha-induced protein 1 antibody; endothelial antibody
-
宿主:Rabbit
-
反應(yīng)種屬:Human,Mouse,Rat
-
免疫原:Fusion protein of Human TNFAIP1
-
免疫原種屬:Homo sapiens (Human)
-
標(biāo)記方式:Non-conjugated
-
抗體亞型:IgG
-
純化方式:Antigen affinity purification
-
濃度:It differs from different batches. Please contact us to confirm it.
-
保存緩沖液:-20°C, pH7.4 PBS, 0.05% NaN3, 40% Glycerol
-
產(chǎn)品提供形式:Liquid
-
應(yīng)用范圍:ELISA,IHC
-
推薦稀釋比:
Application Recommended Dilution ELISA 1:2000-1:10000 IHC 1:50-1:200 -
Protocols:
-
儲(chǔ)存條件:Upon receipt, store at -20°C or -80°C. Avoid repeated freeze.
-
貨期:Basically, we can dispatch the products out in 1-3 working days after receiving your orders. Delivery time maybe differs from different purchasing way or location, please kindly consult your local distributors for specific delivery time.
-
用途:For Research Use Only. Not for use in diagnostic or therapeutic procedures.
相關(guān)產(chǎn)品
靶點(diǎn)詳情
-
功能:Substrate-specific adapter of a BCR (BTB-CUL3-RBX1) E3 ubiquitin-protein ligase complex involved in regulation of cytoskeleton structure. The BCR(TNFAIP1) E3 ubiquitin ligase complex mediates the ubiquitination of RHOA, leading to its degradation by the proteasome, thereby regulating the actin cytoskeleton and cell migration. Its interaction with RHOB may regulate apoptosis. May enhance the PCNA-dependent DNA polymerase delta activity.
-
基因功能參考文獻(xiàn):
- TNFAIP1 silence significantly increased the migrated and invaded cells compared to that in control, while these increases were abolished by miR-424 suppression. PMID: 28535539
- CREB is a negative regulator of the TNFAIP1 gene. PMID: 26398148
- TNFAIP1 plays an important role in mediating miR-15a dependent biological functions in osteosarcoma. PMID: 26261520
- MiR-181a played a critical role in regulating pancreatic cancer growth and migration, likely interacting with TNFAIP1. PMID: 26152285
- Results showed that the expression of TNFAIP1 protein was significantly increased in osteosarcoma tissues and associated with distant metastasis. PMID: 24969828
- Expression of TNFAIP1 is regulated by the transcriptional factor Sp1. PMID: 23912453
- TNFAIP1 inhibited the transcriptional activities of nuclear factor kappa B (NF-kappaB) and activating protein-1 reporters PMID: 22810651
- CK2 could phosphorylate TNFAIP1 in vitro and in vivo, which facilitated the distribution of TNFAIP1 in nucleus and enhanced its interaction with PCNA. PMID: 19851886
- The promoter region of human TNFAIP1 gene was functionally characterized. PMID: 19593659
- suggest that the TNFAIP1/POLDIP2 complex sense-antisense architecture represents a clinically significant transcriptional structural-functional gene module associated with amplification of the genomic region on 17q11.2 in breast cancer. PMID: 20158880
- TNFAIP1 shows increased transcript levels in Alzheimer's disease brains PMID: 12600716
- Expression levels of TNFAIP1 are high in COS7 and NIH3T3 cell lines but low in the cancer cell lines. PMID: 16870576
顯示更多
收起更多
-
亞細(xì)胞定位:Cytoplasm. Nucleus. Endosome. Note=Colocalizes with RHOB in endosomes.
-
蛋白家族:BACURD family
-
數(shù)據(jù)庫鏈接:
Most popular with customers
-
-
YWHAB Recombinant Monoclonal Antibody
Applications: ELISA, WB, IHC, IF, FC
Species Reactivity: Human, Mouse, Rat
-
Phospho-YAP1 (S127) Recombinant Monoclonal Antibody
Applications: ELISA, WB, IHC
Species Reactivity: Human
-
-
-
-
-